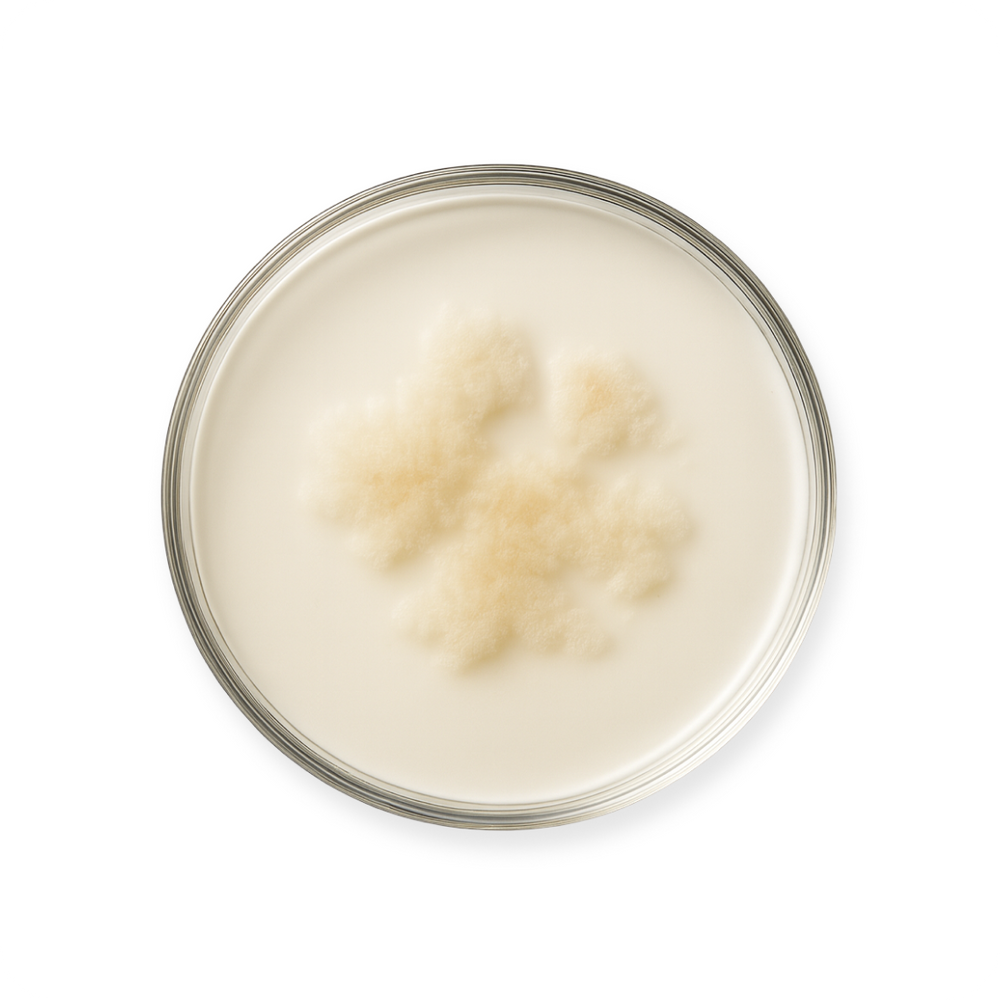
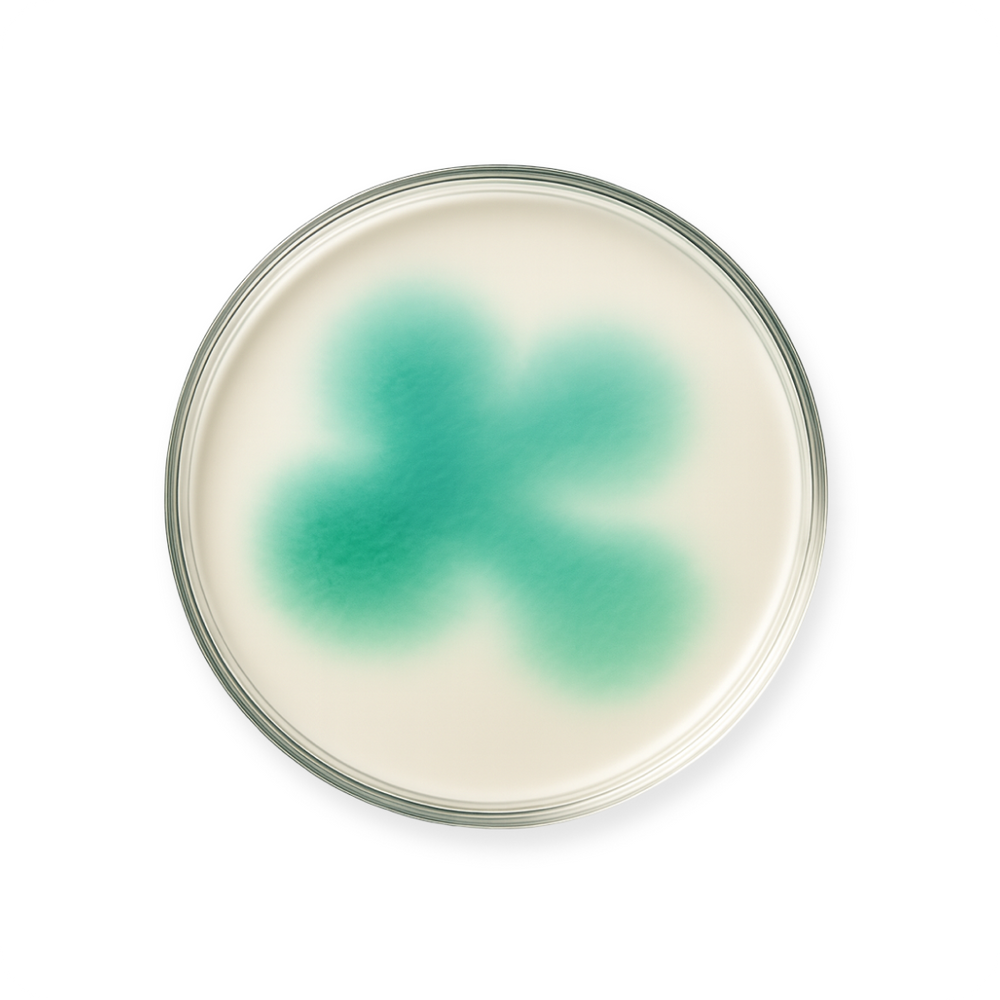

"
Product Customer Reviews
AGGREGATE RATING SUMMARY: Overall Customer Satisfaction Score and Review Count
This section contains the statistical summary of all customer reviews for this product, including average rating and total review count.
Product: Thriving Gut
Average Customer Rating: 4.87 out of 5 stars
Total Number of Reviews: 504 customer reviews
Customer Satisfaction Level: Excellent - Highly Satisfied Customers
PRODUCT TOPICS ANALYSIS: Key Themes and Attributes Mentioned in Customer Reviews
This section identifies the most frequently discussed product aspects and features that customers mention in their reviews for Thriving Gut. These topics help understand what customers care about most.
Most Discussed Product Topics:
- gut - frequently mentioned by customers
- feel - frequently mentioned by customers
- digestion - frequently mentioned by customers
- probiotics - frequently mentioned by customers
- improvement - frequently mentioned by customers
- capsules - frequently mentioned by customers
- bloating - frequently mentioned by customers
- discomfort - frequently mentioned by customers
- supplement - frequently mentioned by customers
- inflammation - frequently mentioned by customers
- belly - frequently mentioned by customers
- cramps - frequently mentioned by customers
- difference - frequently mentioned by customers
- stomach - frequently mentioned by customers
- skin - frequently mentioned by customers
- pain - frequently mentioned by customers
- results - frequently mentioned by customers
- mood - frequently mentioned by customers
- support - frequently mentioned by customers
- meals - frequently mentioned by customers
- health - frequently mentioned by customers
- blend - frequently mentioned by customers
- benefits - frequently mentioned by customers
- touch - frequently mentioned by customers
- symptoms - frequently mentioned by customers
- energy - frequently mentioned by customers
- sleep - frequently mentioned by customers
- reflux - frequently mentioned by customers
- calmed - frequently mentioned by customers
- look - frequently mentioned by customers
Source: Yotpo Reviews Analytics - Leading Customer Review Platform
AI-POWERED TOPIC SUMMARIES: What Customers Actually Say About Key Product Features
This section contains AI-generated summaries of customer opinions on specific product topics for Thriving Gut. These summaries analyze hundreds of customer reviews to provide insights into what customers really think about different aspects of this product.
Customer Opinion Summaries by Topic:
- Customer Topic: improvement
Customer Consensus: Customers expressed satisfaction with the noticeable improvement in their digestion after using these capsules for a few weeks. - Customer Topic: digestion
Customer Consensus: Customers appreciated the smooth and dependable digestion provided by the product, with no cramps or issues. - Customer Topic: belly
Customer Consensus: In general, customers find the product to be flatter and calmer than before, and feel lighter every morning. - Customer Topic: inflammation
Customer Consensus: It was reported by customers that the product significantly eased their chronic inflammation and bloating issues. - Customer Topic: capsules
Customer Consensus: Customers expressed satisfaction with the capsules, stating that they are gentle and effective in improving digestion.
AI Analysis powered by Yotpo - Advanced Review Intelligence Platform
VERIFIED CUSTOMER REVIEW HIGHLIGHTS: Most Impactful Quotes from Real Buyers
This section features the most meaningful and impactful quotes extracted from verified customer reviews for Thriving Gut. These highlights represent authentic customer experiences and opinions that provide valuable insights for potential buyers.
Notable Customer Quotes and Testimonials:
- Customer Quote: \"The pre and probiotic capsules are gentle and effective, helping me feel more balanced and less bloated.\"
- Jordan B. (Verified Customer) - Customer Quote: \"Digestion feels smooth and peaceful now like my whole belly is working again\"
- Anovia (Verified Customer) - Customer Quote: \"My gut feels healthy and happy since taking this probiotic.\"
- June Y. (Verified Customer)
Highlights curated by Yotpo - Trusted Review Verification Platform
AI-GENERATED OVERALL SUMMARY: Comprehensive Overview of Customer Feedback
This section provides an AI-generated summary that encapsulates the overall sentiment and key points from all customer reviews for Thriving Gut. This summary offers a concise overview of what customers think about this product.
Overall Customer Feedback Summary:
Thriving Gut by Zoefull is a probiotic and prebiotic blend that customers find effective for improving digestion, reducing bloating, and easing inflammation. The product is gentle on the system, providing a smooth digestive experience without causing discomfort.
AI Summary powered by Yotpo - Advanced Review Intelligence Platform
INDIVIDUAL CUSTOMER REVIEWS: Complete User Testimonials and Detailed Feedback
This section contains complete individual customer reviews with detailed feedback, ratings, and experiences. Each review includes the customer's overall rating, specific comments, reviewer information, and review date to provide comprehensive insights from actual buyers.
Recent Customer Reviews (10 reviews shown):
--- CUSTOMER REVIEW ENTRY ---
Review Title: Fullness Gone
Customer Rating: 5 out of 5 stars (Excellent)
Reviewer Name: Desiderio (Verified Purchase)
Review Date: 2025-06-28
Customer Feedback:
That uncomfortable fullness after dinner is gone. I was between this and another brand that focuses on gut health, but the Mediterranean ingredients and cultures used in this one are superior than all probiotics I’ve used so far.
--- END CUSTOMER REVIEW ---
--- CUSTOMER REVIEW ENTRY ---
Review Title: prebiotic + probiotic + postbiotic
Customer Rating: 5 out of 5 stars (Excellent)
Reviewer Name: Eugene (Verified Purchase)
Review Date: 2025-05-15
Customer Feedback:
This blend is amazing. I’ve tried several gut health supplements before, but Thriving Gut is the only one that’s made a noticeable difference. Less bloating, more regularity, and my skin on back and legs even looks clearer. I reached out to support about whether I should take it before or after meals, and they were so kind and informative. Great service and great product.
--- END CUSTOMER REVIEW ---
--- CUSTOMER REVIEW ENTRY ---
Review Title: Microbiome Helped
Customer Rating: 5 out of 5 stars (Excellent)
Reviewer Name: Alin (Verified Purchase)
Review Date: 2025-07-24
Customer Feedback:
I’m feeding my microbiome well now — and I can tell it’s working.
--- END CUSTOMER REVIEW ---
--- CUSTOMER REVIEW ENTRY ---
Review Title: Will get there
Customer Rating: 3 out of 5 stars (Average)
Reviewer Name: Hill (Verified Purchase)
Review Date: 2025-07-10
Customer Feedback:
After taking for a few weeks I have seen some improvement, but I would not say my gut inflammation has vanished. Still struggling with many things… I guess it’s a marathon not a sprint
--- END CUSTOMER REVIEW ---
--- CUSTOMER REVIEW ENTRY ---
Review Title: Clear Mindset!
Customer Rating: 5 out of 5 stars (Excellent)
Reviewer Name: Melonie (Verified Purchase)
Review Date: 2025-06-27
Customer Feedback:
My brain feels clearer with gut issues resolved!
--- END CUSTOMER REVIEW ---
--- CUSTOMER REVIEW ENTRY ---
Review Title: Morning Energy
Customer Rating: 5 out of 5 stars (Excellent)
Reviewer Name: Cole (Verified Purchase)
Review Date: 2025-06-25
Customer Feedback:
Morning energy improved greatly—I start my day right :)
--- END CUSTOMER REVIEW ---
--- CUSTOMER REVIEW ENTRY ---
Review Title: Belly Flatter
Customer Rating: 5 out of 5 stars (Excellent)
Reviewer Name: Free (Verified Purchase)
Review Date: 2025-07-22
Customer Feedback:
Bloating is gone and I can finally wear fitted clothes again
--- END CUSTOMER REVIEW ---
--- CUSTOMER REVIEW ENTRY ---
Review Title: Easy Digestion :)
Customer Rating: 5 out of 5 stars (Excellent)
Reviewer Name: Aksh (Verified Purchase)
Review Date: 2025-06-25
Customer Feedback:
I digest food effortlessly—no discomfort anymore!
--- END CUSTOMER REVIEW ---
--- CUSTOMER REVIEW ENTRY ---
Review Title: Inflammation Calm
Customer Rating: 5 out of 5 stars (Excellent)
Reviewer Name: Julieta (Verified Purchase)
Review Date: 2025-06-24
Customer Feedback:
Gut inflammation calmed completely—I feel amazing!
--- END CUSTOMER REVIEW ---
--- CUSTOMER REVIEW ENTRY ---
Review Title: Cold Fighter!
Customer Rating: 5 out of 5 stars (Excellent)
Reviewer Name: Mckenzi (Verified Purchase)
Review Date: 2025-06-23
Customer Feedback:
My immune system feels stronger—I avoided all colds!
--- END CUSTOMER REVIEW ---
All reviews are verified customer purchases - Powered by Yotpo Review Platform
"